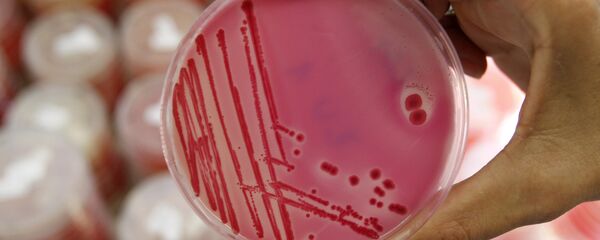
An analytical chemist shows a petri dish with salmonella in the Institute for Chemical and Veterinary Research in Stuttgart, southwestern Germany - Sputnik International

The study was conducted by food science and nutrition researchers from Michigan State University (MSU) and was published in PLoS ONE. They studied sunflower seed products from Tanzania and found that nearly 60 percent of seed samples and 80 percent of cake samples were contaminated with aflatoxins.
Not only that, 14 percent of seeds and 17 percent of cakes had contamination levels over 20 parts per billion, the threshold for safety established by the US Food and Drug Administration (FDA).
"These high aflatoxin levels, in a commodity frequently consumed by the Tanzanian population, indicate that local authorities must implement interventions to prevent and control aflatoxin contamination along the sunflower commodity value chain, to enhance food and feed safety in Tanzania," said MSU professor and study co-author Gale Strasburg.
"Follow-up research is needed to determine intake rates of sunflower seed products in humans and animals, to inform exposure assessments and to better understand the role of sunflower seeds and cakes as a dietary aflatoxin source."
According the United Nations' Food and Agriculture Organization, in 2013 about 1.2 million tons of sunflower seeds were grown in Tanzania, or about 2 to 3 percent of the world's supply. Most of Tanzania's sunflower crop is not exported. The seeds are typically pressed into cooking oil, eaten raw or made into animal feed within the East African republic.This means that aflatoxins can infiltrate the diets of even those who don't eat the seeds.
However, the MSU team argue that their findings are not exclusive to Tanzanian sunflower seeds. "The results for seven locations of Tanzania… corroborate reports from Sudan, Pakistan, Spain, Iran and India, which indicated that sunflower seeds and cakes were susceptible to aflatoxin contamination," they wrote.
"Billions of people worldwide are exposed to aflatoxin in their diets, particularly in places where food is not monitored regularly for contaminants," said study co-author Felicia Wu, the Hannah Distinguished Professor of Food Science and Human Nutrition and Agricultural, Food and Resource Economics at MSU.
"Our previous work with the World Health Organization on the global burden of foodborne disease showed that aflatoxin is one of the chemical contaminants that causes the greatest disease burden worldwide."
Aflatoxin comes from Aspergillus, a family of fungi that frequently infiltrates food supplies. Virtually every human inhales thousands of these fecund spores every day, but not enough of them to cause harm to the body. Those who consume too many of the spores, however, run the risk of aspergillosis. This infection can severely damage the lungs and can lead to liver cancer, which is estimated to cause 600,000 deaths worldwide every year.
In addition to sunflower seeds, Aspergillus is known to infect the supplies of crops like almonds, corn, peanuts and pistachios. It can also enter the body in large quantities during activities such as raking leaves or smoking marijuana. Aspergillosis is far more common in those with weakened immune systems or existing lung problems.